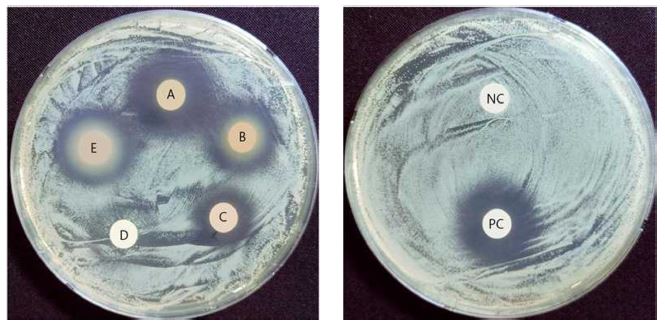
Fig. 3.

차나무 부위별 추출물의 미백, 주름 개선과 피부보호 효과
This is an open access article distributed under the terms of the Creative Commons Attribution Non-Commercial License (http://creativecommons.org/licenses/by-nc/3.0/) which permits unrestricted non-commercial use, distribution, and reproduction in any medium, provided the original work is properly cited.
Abstract
Camellia sinensis is globally cultivated, principally for the leaves which are used as a green tea. Green tea made from C. sinensis leaves contains various physiologically active ingredients and is used for health and beauty purposes; however, most parts of the plant are discarded. In this experiment the physiological activity of each part of the C. sinensis was analyzed to confirm its potential for use as a cosmetic raw material.
Leaves, flowers, roots, branches, and seeds were extracted with 70% ethyl alcohol. Experiments were performed to measure, tyrosinase inhibitory activity, elastase inhibitory activity, antibacterial activity, and cell viability upon ultraviolet B (UVB)-induced cell damage. Tyrosinase inhibitory activity was high in leaves, flowers, and roots, and elastase inhibitory activity showed high inhibition rates in roots, leaves, and branches. Antibacterial activity against Propionibacterium acnes was highest in leaves and roots, followed by branches and flowers, with no antibacterial activity found in seeds. In terms of the protective effect from UVB irradiation induced damage, the experimental group treated with the seed extract in HaCaT cells showed a high survival rate. In Detroit cells, an increased survival rate was observed in most of the experimental groups treated with the extracts, particularly those treated with the seed and flower extracts.
Experiment results suggest various parts of the C. sinensis, could be used as raw materials for cosmetics.
Keywords:
Camellia sinensis, Antibacterial, Elastase, Tyrosinase, Ultraviolet B서 언
화장품 산업은 지난 10 년간 지속적으로 성장을 거듭해왔다. 의학기술의 발전과 대중매체 등의 영향으로 인해 개개인의 외모에 대한 관심도는 증가하고 있으며 현대인들은 더 젊어보이고 싶어하는 욕구를 충족하기 위해 더 많은 노력과 비용을 소비하고 있다. 하지만 최근에는 화장품 제조에 들어가는 성분에 대해 소비자들의 관심도가 높아지고 합성 화합물질로 인한 환경파괴와 피부 부작용에 대한 보고가 이어지면서 합성물질의 사용을 기피하고 있으며 안전성과 기능성이 높은 천연물을 활용한 화장품을 선호하고 있는 추세이다 (Nigam, 2009; Bom et al., 2019).
차나무 (Camellia sinensis)는 상록 활엽관목 다년생으로 강수량이 적당하고 배수가 잘되는 지역에서 잘 자라며 주로 아열대 및 온대 지방에서 재배하고 있다. 차나무 재배는 중국에서 시작되었고 이후 인도, 스리랑카 등으로 재배 지역이 점차 확장되었으며 현재는 약 30 개국 이상의 지역에서 재배하고 있고 차나무 잎을 녹차로 가공하여 전세계적으로 많이 음용하고 있다 (Vishnoi et al., 2018).
녹차에는 다양한 생리활성 물질이 함유되어 있기 때문에 고대부터 건강과 미용 등을 목적으로 섭취해 왔으며 현재는 건강기능식품, 화장품 등 산업계에서 다양한 제품으로 개발하여 소비하고 있다. 녹차에는 다양한 폴리페놀 성분이 함유되어 있는데 그 중 catechin류 화합물이 약 70%를 차지하는 것으로 알려져 있으며 catechin의 종류로는 epicatechin (EC), epicatechin gallate (ECG), epigallocatechin (EGC), epigallocatechin gallate (EGCG), gallocatechin (GC) 및 gallocatechin gallate (GCG) 등이 함유되어 있다 (Moore et al., 2009; Paiva et al., 2020). 녹차 유래 catechin 화합물은 천연 항산화제로서 다양한 효능이 있으며, 녹차에 가장 많이 들어있다고 알려진 EGCG는 강력한 항산화제 성분으로 암과 같은 치명적인 질병을 예방하고 항균 등의 효과가 있는 것으로 보고되었다 (Hodgson et al., 1999; Gan et al., 2018).
최근 기후 변화로 인해 전 세계적인 피해가 증가함에 따라 이를 조금이라도 개선하기 위해 낭비되는 자원을 줄이고 폐자원을 재활용하고자 하는 움직임이 점차 커지고 있다. 하지만 차나무는 주로 잎을 녹차로 가공하여 소비하고 있으며 녹차의 품질과 생산성을 위해 주기적인 전정 작업 중에 발생하는 부산물인 가지, 꽃, 씨 등의 부위는 대부분이 폐기자원으로 분류되어 버려지고 있다 (Zhang et al., 2021).
특히 차나무 꽃을 제거하면 다음 해의 찻잎의 수확량과 품질이 30% 정도 향상되기 때문에 농가에서는 acetic acid, ethephon, α-naphthalene 등 화학 물질을 사용하여 차나무 꽃의 개화를 억제하고 있다 (Chen et al., 2018). 중국에서는 연간 4 백만 톤 이상을 수확할 수 있지만 대부분의 꽃을 폐기하고 있는 실정이며 이를 산업적으로 활용하기 위한 방안을 개발하는 것이 시급하다 (Lin et al., 2003; Chen et al., 2018).
차나무에 관한 연구를 확인해보면 차나무 잎에는 병원성 세균에 대해 항부착효과가 있어서 Bacillus subtilis, Brevibacterium linens, Micrococcus luteus, Pseudomonas fluorescens, Staphylococcus epidermidis 등 박테리아에 대한 항균활성을 나타낸다는 연구 결과가 있다 (Sharma et al., 2012). Hajiaghaalipour 등 (2013)의 연구에서는 마우스 모델에서 피부조직 손상에 대해 차나무 추출물을 처리했을 경우 콜라겐의 합성과 섬유아세포가 증식하였으며 상처 치유 속도를 증진시켰다는 보고가 있다. 이 외에도 차나무 잎에는 항노화 활성, 주름개선, 미백 등의 효능이 있으며 산업계에서도 화장품 원료로 활발하게 이용하고 있기 때문에 화장품 소재로서 활용도가 높다는 것을 확인할 수 있다 (Lee et al., 2014; Dissanayake et al., 2018; Chaikul et al., 2020).
잎 외의 다른 부위에 대한 선행연구를 찾아보면 차나무 꽃에는 diglycosides, kaempferol, myricetin, quercetin 등의 플라보놀 배당체와 다양한 종류의 다당류, 사포닌이 함유되어 있으며 (Yang et al., 2009; Chen et al., 2020), Yoshikawa 등 (2005)은 항고지혈증 효과가 있는 floratheasaponins 성분을 차나무 꽃에서 처음으로 발견하였다. Na 등 (2018)의 연구에서는 차나무 뿌리를 70% 에탄올로 추출했을 경우 총 순수 사포닌이 54% 함유되어 있으며, 미세먼지로 인해 발생하는 피부 손상에 대해 보호 효과가 있음을 보고하였다. 그 외에도 뿌리와 씨 부위에는 잎에 존재하지 않은 phenylalanine 성분을 비롯한 다양한 비타민과 페놀 화합물 들어있는 것으로 확인되었다 (Cha et al., 2008).
또한 앞선 연구에서 폐기되고 있는 자원인 차나무 꽃, 뿌리, 가지, 씨 등 부위에서도 EC, EGC, EGCG, GC, GCG 등의 catechin 화합물이 함유되어 있고, 항산화 및 항당뇨 활성 등이 확인되어 잎 외의 꽃, 뿌리, 가지, 씨 등도 산업적인 활용 가치가 있을 것으로 판단하고 있다 (Im and Kim, 2022). 하지만 현재까지 차나무에 관한 연구는 주로 잎에 대한 연구가 진행되어 왔으며 다른 부위에 대한 연구는 상대적으로 소홀히 다루어져 왔다. 근래에 들어서는 중국과 일본을 중심으로 잎 외의 다른 부위에도 효능 및 유효성분이 있다는 것이 점차 밝혀지고 있으며, 앞으로는 차나무의 다른 부위에 대한 관심과 연구의 범위가 더욱 확장될 것으로 보인다. 그리고 소비자들의 환경에 대한 관심도가 높아짐에 따라 현재 폐기되는 다른 부위들에 대한 연구 및 산업적 활용 가능성 또한 점차 높아지고 있다.
본 연구에서는 폐기되는 자원인 꽃, 뿌리, 가지, 씨 등의 부위를 순환자원으로 활용하기 위해 각 부위를 70% 에탄올로 추출한 뒤 tyrosinase 및 elastase 저해 활성, 여드름 유발균에 대한 항균 활성 및 UVB 유도성 세포손상 보호 효과 등의 실험을 수행하였으며 산업계에서 주로 이용되고 있는 잎과의 비교 분석을 통해 생리활성에 대한 검증을 진행하여 화장품 원료로서의 활용 가능성을 확인하였다.
재료 및 방법
1. 실험 재료
본 실험에 사용한 차나무 (Camellia sinensis)는 제주도 서귀포시에 위치한 제주다원에서 직접 채취하여 실험 시료로 사용하였다. 차나무 잎, 꽃, 뿌리, 가지, 씨를 채취하기 위해 제주다원의 구역을 나누어 각각 다른 날짜에 3 회 반복하여 채취한 뒤 48 시간 동안 60℃에서 열풍건조기 (PFC-P0-91, Nihon-freezer, Namyangju, Korea)를 활용하여 건조하였다. 건조된 시료는 믹서기를 사용하여 분말화한 후 실험에 사용하였다.
2. 추출물 제조
차나무 잎, 꽃, 뿌리, 가지, 씨를 각각 15 g 씩 취하고 300 ㎖의 70% ethyl alcohol을 가한 후 초음파세척기 (Powersonic 520, Hwashin Technology, Seoul, Korea)를 활용하여 1 시간 동안 추출한 뒤 filter paper로 여과하였고 이 과정을 3 회 반복하였다. 여과된 추출물은 회전식 감압농축기 (Hei-VAP Precision, Heidolph, Schwabach, Germany)로 농축 후 동결건조하여 실험에 사용하였다.
3. Tyrosinase 저해 활성 측정
Tyrosinase 저해 활성은 Ko 등 (2018)의 방법을 변형하여 측정하였으며 tyrosinase에 의해서 발생된 dopachrome의 양을 기질인 tyrosine을 활용하여 측정하였다.
실험에 사용할 혼합액은 증류수, 50 mM potassium phosphate buffer (pH 6.5), 1 mM의 L-tyrosine 각각을 9 : 10 : 10 비율로 섞어 제조하였다. 96-well plate에 차나무 부위별 추출물 10 ㎕에 상기 제조한 혼합액 170 ㎕를 넣고 1 KU/㎖ tyrosinase (Sigma-Aldrich Co., St. Louis, MO, USA) 20 ㎕를 가하여 37℃에서 20 분간 반응시켰다. 이후 microplate reader (i-Mark 168-1135, Bio-Rad Inc., Hercules, CA, USA)를 이용하여 490 ㎚에서 흡광도를 측정한 뒤에는 각 부위의 농도별 활성을 저해율 (%)로 표기하였다.
4. Elastase 저해 활성 측정
차나무 부위별 추출물의 elastase 저해 활성은 Ko 등 (2018)의 방법을 참고하여 측정하였다. 차나무 부위별 추출물 20 ㎕를 50 mM Tris-HCl buffer (pH 8.0) 120 ㎕로 희석한 뒤 elastase (Sigma-Aldrich Co., St. Louis, MO, USA)를 1 U/㎖ 농도 10 ㎕와 elastase 기질 1 mM N-succinyl-(Ala)3-p-nitroanilide를 혼합하여 37℃ 조건으로 20 분 동안 반응하였다. 이후 microplate reader로 415 ㎚에서 흡광도를 측정하였고 elastase 저해 활성을 %로 표기하였다.
5. 여드름 유발균에 대한 항균 실험
본 실험에 사용한 미생물은 여드름균인 Propionibacterium acnes (P. acnes, KACC No. 11946)를 농촌진흥청 국립농업 과학원 농업미생물과 (Wanju, Korea)에서 분양받아 사용하였으며 균의 배양에는 reinforced clostridial medium (RCM) 액체배지 및 고체배지를 제조하여 사용하였다.
여드름균 항균 실험을 위해 P. acnes 균을 RCM 액체배지에서 계대배양을 2 회 반복하여 활성화시킨 후 원심분리하여 상층액을 제거하였고 다시 멸균수에 첨가하여 희석한 뒤 접종 밀도를 105 CFU/㎖의 농도로 조정한 현탁액 100 ㎕를 RCM 고체배지에 도말하였다. 이후 paper disc (8 ㎜/1.5 ㎜, Advantec, Matsuyama, Japan)에 양성대조군인 erythromycin (Daejung Chemicals, Siheung, Korea)을 10 ㎍/㎖ 농도로, 차나무 부위별 추출물을 각각 100 ㎎/㎖ 농도로 40 ㎕ 씩 접종한 뒤 37℃ incubator (BINDER GmbH, Tuttlingen, Baden-Württemberg, Germany)에서 혐기조건으로 배양하였다.
RCM 고체배지에서 paper disc를 이용한 생육 저지환의 크기를 측정하여 평가하였으며 모든 실험은 3 회 반복하여 항균 활성을 확인하였다.
6. 세포손상 보호능 평가
HaCaT (Human keratinocyte, CLS, 330493, American Type Culture Collection, Rockville, MD, USA) 세포와 Detroit 551 (Human fibroblast, CCL-110, American Type Culture Collection, Rockville, MD, USA) 세포를 배양 접시의 바닥에 접종한 후 100 units/㎖ penicillin (Thermo Fisher Scientific Inc., Waltham, MA, USA), 100 ㎍/㎖ streptomycin (Thermo Fisher Scientific Inc., Waltham, MA, USA), 10% fatal bovine serum (FBS, Thermo Fisher Scientific Inc., Waltham, MA, USA)를 함유하는 동물세포 배지인 dulbecco modified eagle medium (DMEM, Corning Inc., Corning, NY, USA)을 넣고 37℃, 5% CO2 조건인 항온기 (VS-2050C, Vision Science Co., Ltd., Gyeongsan, Korea)에서 배양하였다.
피부세포 독성 평가를 위해 HaCaT 세포와 Detroit 세포를 96-well plate에 분주한 후 세포 배양 조건에서 24 시간 배양하였다. 24 시간 후 혈청이 함유되지 않은 DMEM과 함께 차나무 부위별 추출물을 희석하여 최종 농도 0.5, 1.0, 2.0, 5.0, 10.0 ㎍/㎖가 되도록 세포에 처리하고 24 시간 동안 추가 배양하였다.
이후 cell counting kit (CCK) 용액 (Dongin LS, Hwaseong, Korea)을 10 ㎕/well 씩 첨가하고 4 시간 동안 배양한 후 spectrophotometer (Thermo Fisher Scientific Inc., Waltham, MA, USA)를 사용하여 450 ㎚에서 흡광도를 측정하고 세포 생존율을 계산하였다.
본 실험에서는 UVB에 의한 자극을 조사하여 피부 세포의 손상 정도를 확인하였다. HaCaT 세포와 Detroit 세포를 96-well plate에 분주한 후 세포 배양 조건에서 24 시간 동안 배양하였다.
24 시간 후 FBS를 포함하지 않는 배지로 교체한 후 4 시간 동안 starvation하고, UVP (CL-1000, Analytik Jena US LLC, Germany)를 사용해 UVB 5 mJ/㎠를 조사하고, 대조군과 차나무 부위별 추출물을 농도별로 세포에 처리하여 24 시간 동안 추가 배양하였다.
이어 UVB 유도에 의한 피부세포의 손상을 보호하는지 확인하고자 CCK assay를 이용하여 세포 생존율을 측정하였다.
7. 통계처리
본 연구의 실험은 3 회 반복하여 실시하였고, 통계분석은 SPSS 18.0 (SPSS Inc., Chicago, IL, USA)를 사용하여 Duncan의 다중범위검정 (Duncan’s Multiple Range Test, DMRT)과 t-test를 실시함으로써 통계학적으로 유의성을 분석하였다 (*p < 0.05).
결과 및 고찰
1. 차나무 부위별 추출물의 tyrosinase 저해 활성
피부는 자외선, 미세먼지 등의 외부적인 요인에 의한 자극을 받기 쉬운 기관이다. 자외선 등의 의해 자극을 받은 피부는 세포의 손상을 억제하기 위해 멜라닌이 생성되어 색소 침착이 증가하게 된다. 하지만 멜라닌이 과도하게 증식하게 되면 기미, 주근깨, 피부병, 피부 변색 등을 유발할 수 있기 때문에 멜라닌 생성을 억제하는 것은 피부 미백에 있어서 매우 중요한 요소이며 멜라닌 생성에서 가장 중요한 역할을 하는 효소인 tyrosinase를 저해하는 방법에 관한 연구가 활발하게 진행되고 있다 (Prota, 1980; You et al., 2009; Tu and Tawata, 2015).
차나무 (Camellia sinensis) 부위별 추출물의 tyrosinase의 효소 저해 활성은 tyrosinase에 의해서 생성된 dopachrome의 양을 측정하여 tyrosinase 저해율 (%)로 나타내었다 (Fig. 1). 차나무 부위별 추출물의 저해 활성은 농도에 따라 증가하는 경향성을 보이고 있으며, 잎, 꽃, 뿌리에서 가장 높은 저해 활성을 나타내었고 1.25 ㎎/㎖ 농도부터는 모두 50% 이상의 저해율이 확인되었다. 그에 반해 가지와 씨는 모든 농도에서 50% 미만의 저해 활성이 확인되었다.

Tyrosinase inhibitory activity of extracts from different parts of C. sinensis (A) and arbutin (B).*Means with different letters (a-d) in the same column are significantly different by Duncan’s Multiple Range Test (DMRT, p < 0.05). Values are means ± SD (n = 3).
선행 연구인 Im과 Kim (2022)의 연구에서 차나무 부위별 추출물의 총 페놀 함량은 잎, 뿌리, 가지, 꽃, 씨 순서로 확인되어 꽃을 제외하면 본 실험에서 나타난 저해 활성과 유사한 경향을 보여주고 있다. 항산화 활성과 유기적인 상관관계가 있다고 알려진 페놀 화합물을 이용하여 인간 피부 세포의 활성 산소를 억제한다면 피부 노화를 지연시킬 수 있으며, 차나무 부위별 추출물의 tyrosinase 저해 활성은 선행 연구를 참고했을 때 페놀 화합물이 관여 (0.658, p ≤ 0.01)하고 있는 것으로 생각한다 (Jiang et al., 2006; Im and Kim, 2022).
다만 페놀 함량과 다른 경향을 보인 꽃 추출물에서는 페놀 화합물이 아닌 tyrosinase 저해율에 영향을 주는 비페놀성 화합물이 함유되어 있음을 고려해볼 수 있으며, Jiang 등 (2006)의 연구에서도 Pyracantha koidzumii 추출물에서 높은 tyrosinase 저해 활성을 확인하였지만, 반대로 페놀 함량은 낮은 값을 나타내어 멜라닌 합성을 저해하는데 비페놀성 화합물이 관여한 것으로 생각된다. 이를 통해 후속 연구로, 차나무 꽃 추출물에 tyrosinase 저해 활성에 관여하는 비페놀성 화합물에 관한 연구가 필요할 것으로 생각한다.
또한 본 실험에서 나타난 차나무 부위별 추출물의 tyrosinase 저해 활성은 양성대조군으로 사용한 arbutin 보다는 다소 낮은 활성을 나타내었는데, 녹차는 화장품 업계에서 미백 원료로 사용하고 있고 실제로도 녹차 추출물이 미백 활성을 나타내는 것으로 알려져 있다고 보고된 것과 (Korkmaz et al., 2019) 서로 상이한 결과를 나타내었다.
2. 차나무 부위별 추출물의 elastase 저해 활성
피부 진피 속에는 피부 탄력을 조절하는 불용성 탄성 섬유 단백질인 elastin이 그물망 구조를 형성하고 있는데 분해 효소인 elastase로 인해 elastin이 분해되면 그물망 구조가 깨지면서 피부가 처지거나 주름이 생기는 등 피부 노화가 발생한다 (Kwak et al., 2005). 근래에는 주름 생성을 억제함으로써 피부 노화를 방지하기 위한 연구의 일환으로 elastase의 활성을 억제하는 물질에 대한 탐색이 지속적으로 이루어지고 있다.
차나무 부위별 추출물의 elastase 저해 활성은 저해율 (%)로 나타내었다 (Fig. 2). 차나무 부위별 추출물의 elastase 저해 활성은 0.125 ㎎/㎖ 농도에서부터 2.500 ㎎/㎖ 농도까지 모든 시료에서 저해율이 증가하는 경향을 보였으며, 특히 뿌리 추출물의 농도 0.625 ㎎/㎖부터는 모두 50% 이상의 저해 활성을 보여주었다. 뿌리 다음으로는 잎과 가지에서 저해 활성이 높았고, 꽃과 씨의 모든 농도에서는 50%보다 낮은 저해율이 확인되었다.

Elastase inhibitory activity of extracts from different parts of C. sinensis (A) and ursolic acid (B).*Means with different letters (a - d) in the same column are significantly different by Duncan’s Multiple Range Test (DMRT, p < 0.05). Values are means ± SD (n = 3).
Shin 등 (2014)의 연구에서 꾸지뽕나무 부위별 추출물의 elastase 저해 활성이 본 실험과 유사하게 뿌리와 잎에서 높게 나타났으며, Im과 Kim (2022)의 연구에서는 차나무의 각 부위를 70% 에탄올로 추출한 후 총 페놀 함량을 측정하였을 때 잎, 뿌리, 가지, 꽃, 씨 순서로 높게 나타난다고 보고한 바, 본 실험의 결과에서도 매우 유사한 경향성을 나타내었다.
선행 연구에서 측정한 총 페놀 함량과의 상관관계를 확인하기 위해 피어슨 상관계수를 측정한 결과, 차나무 부위별 추출물의 총 페놀 함량과 elastase 저해율은 양의 상관관계 (0.838, p ≤ 0.01)를 나타내어 차나무 부위별 추출물의 elastase 저해 활성은 차나무에 함유된 페놀 화합물에 기인한 것으로 생각한다. 또한 본 실험에서 나타난 결과는 양성대조군으로 사용한 ursolic acid보다 낮은 활성을 보여주고 있는데, 산업계에서 차나무 잎을 화장품 원료로 사용하는 점이나 선행 연구를 통해 알려진 효능보다 활성이 낮은 것은 차나무를 채취한 시기나 지역적 차이에 의한 것으로 생각되며, 본 실험 결과에서 차나무 잎보다 뿌리에서 더 높은 저해 활성을 확인하였으므로 시기적, 지역적 차이가 있는 다른 차나무 원료에서도 잎보다 뿌리에서 더 높은 elastase 저해 활성을 나타낼 것으로 생각한다 (Lee et al., 2015).
3. 차나무 부위별 추출물의 여드름 유발균에 대한 항균 활성
P. acnes는 혐기성 세균으로 피부의 피지나 각질이 쌓여서 피부 안이 혐기조건이 되면 그 수가 급격히 증가하게 되며 P. acnes에서 분비되는 lipase가 중성지방을 분해하고 유리지방산을 생성하여 염증반응 촉진을 통해 여드름 증상이 유발되는 것으로 알려져 있다 (Higaki, 2003; Weon et al., 2011).
차나무 부위별 추출물의 여드름균 생육 억제환을 측정한 결과 씨를 제외한 모든 추출물에서 P. acnes 균에 대한 억제 활성이 확인되었다 (Table 1 and Fig. 3).
The inhibition zone of extracts from different parts of C. sinensis against P. acnes.A – E; extraction samples (100 ㎎/㎖) from different parts [leaf (A), branch (B), flower (C), seed (D), and root (E)] of C. sinensis. NC; solvent, PC; erythromycin (10 μg/㎖).
차나무 잎, 뿌리에는 각각 22.7 ㎜, 21.0 ㎜로 양성대조군인 erythromycin (21.4 ㎜)과 유사한 항균 활성을 나타내었으며, 그 다음으로 가지 (18.6 ㎜), 꽃 (15.3 ㎜) 순서로 높은 활성이 확인되었다. Lee 등 (2009)의 연구에서 차나무 잎 추출물이 세균의 세포질막을 손상시켜 세포에 대한 세균의 접착력을 저해할 수 있으며 특정 병원성 박테리아에 대한 항부착 효과를 나타내는 것으로 확인되었다. 이는 차나무 잎에 함유된 EGCG가 세균의 세포벽에 직접 부착하여 세포벽이나 세포질 효소, 막단백질 등을 손상시키는 원리에 기인하는 것으로 판단된다 (Rahardiyan, 2019). 또한 같은 매커니즘으로 차나무 추출물이 Pseudomonas fluorescens, B. subtilis 등 피부 병원균에 대해 항균 활성을 나타낸다는 보고가 있다 (Sharma et al., 2012).
Lee 등 (2020)의 연구에서 생강의 잎, 줄기, 뿌리를 70% 에탄올로 추출하여 P. acnes에 대한 저해 활성을 측정했을 때 본 실험과 유사하게 잎, 줄기, 뿌리의 부위에서 높은 항균 활성이 확인되었고, Im과 Kim (2022)의 연구에서는 차나무 부위별 추출물의 총 폴리페놀 및 항산화 활성이 잎, 뿌리, 가지, 꽃, 씨 순서로 나타났으며, 본 실험의 경향과 일치함을 확인할 수 있었다.
4. 차나무 부위별 추출물의 UVB 유도성 세포손상 보호능
기능성 화장품 원료를 탐색하는 과정에서 우선적으로 고려해야할 것은 피부를 구성하고 있는 세포종들에게 세포독성을 나타내지 않은 농도 범위를 선정해야 한다. 추출물의 피부 세포독성 범위를 측정하기 위해 CCK assay로 실제 피부 세포인 HaCaT 세포와 Detroit 세포를 배양하면서 차나무 부위별 추출물을 처리하였고 세포 성장 및 증식에 대한 영향을 조사하였다. CCK 용액의 기질인 water soluble tetrazolium salt (WST)는 미토콘드리아 전자전달계에 있는 탈수소효소 (dehydrogenase)와 반응하여 환원되고, 황색의 수용성 formazan이라는 발색물질을 생성한다. 세포 탈수소효소에 의해 생성된 formazan은 살아있는 세포 수와 유의한 상관관계를 가지며, 이 는 흡광도를 측정함으로써 알 수 있다 (Cai et al., 2019).
차나무 부위별 추출물의 세포 생존율은 Fig. 4와 같은 수치로 나타내었다. 차나무 씨 추출물은 0.5 ㎍/㎖ - 1.0 ㎍/㎖에서는 세포독성을 나타내지 않았고 2 ㎍/㎖ 농도에서는 HaCaT 세포와 Detroit 세포에서 각각 77.2%, 87.3%의 세포 생존율을 나타내었다. 뿌리 추출물에서는 1 ㎍/㎖ - 5 ㎍/㎖에서는 세포 독성을 보이지 않았으나 10 ㎍/㎖ 농도에서 HaCaT세포와 Detroit 세포에서 78.2%, 43.2%로 세포 생존율이 낮아졌고, 나머지 부위별 추출물에서는 1 ㎍/㎖ - 10 ㎍/㎖ 농도에서 세포 독성이 확인되지 않았다.

Cell viability of HaCaT (A) and Detroit (B) cells of extracts from different parts of C. sinensis.Con; control, Significant difference compared with control by t-test as means ± SD (n = 3) (*p < 0.05, **p < 0.01, and ***p < 0.001).
Choi 등 (2019)의 연구에서 오미자 종자 분획물과 EGCG의 HaCaT 세포에 대한 생존율은 10 ㎍/㎖ 농도에서 모두 40% 이하의 세포 생존율을 보여주어, 본 실험에서 사용한 차나무 부위별 추출물의 세포 생존율이 더 높은 것으로 확인되었다.
자외선 (Ultraviolet, UV)은 햇빛에서 나오며 10 ㎚ - 400 ㎚의 파장대를 가진 모든 전자기적 방사에너지를 말한다. 자외선의 영역은 크게 UVA, UVB와 UVC로 나눌 수 있는데 UVC (200 ㎚ - 280 ㎚)는 오존층에 의해 거의 흡수되지만 UVA (320 ㎚ - 400 ㎚)와 UVB (280 ㎚ - 320 ㎚)는 지표까지 도달해 생물체의 피부세포에 영향을 끼친다 (Diffey, 2002). 특히 생물체 피부암의 90% 정도의 원인은 UVB로부터 유래한다고 알려져 있으며 UVB는 표피의 기저 세포층에 주로 작용하고 장기간 노출 시에는 피부 주름, 피부암 등의 부작용을 유발한다 (Imokawa and Ishida, 2015).
HaCaT 세포에서 UVB 조사 후 차나무 부위별 추출물의 세포 생존율은 Fig. 5와 같은 수치로 확인되었다. HaCaT 세포에 UVB를 조사했을 경우 대조군의 생존율은 54%로 확인되었으며, 차나무 씨 추출물을 처리했을 경우에는 0.5 ㎍/㎖ - 2.0 ㎍/㎖ 농도에서 85.93% - 86.63%로 대조군 대비 생존율이 증가하였다. 나머지 추출물에서는 대조군보다 조금 더 높은 생존율을 보여주었으나 차나무 뿌리 추출물의 10 ㎍/㎖ 농도에서 44.1%로 생존율이 감소하였다.

Cell viability on UVB-induced cell damage in HaCaT (A) and Detroit (B) cells of extracts from different parts of C. sinensis.Con: Control, Significant difference compared with control by t-test as means ± SD (n = 3). *(p < 0.05), **(p < 0.01) and *** (p < 0.001) represents the compared between Con (+) and samples and †††(p < 0.001) represents the compared between Con (+) and Con (-).
Detroit 세포에 UVB 조사했을 경우 대조군의 생존율은 37.89%로 확인되었으며, 차나무 씨 추출물의 0.5 ㎍/㎖ 농도에서 59.11%로 생존율이 증가하였지만 1.0 ㎍/㎖에서 53.90%, 2.0 ㎍/㎖에서 37.77%로 농도가 증가함에 따라 생존율은 감소하는 경향을 나타내었다. 뿌리 추출물에서도 마찬가지로 1.0 ㎍/㎖에서 46.75%로 증가하였지만 농도가 5, 10 ㎍/㎖으로 증가함에 따라 생존율은 감소하여 10 ㎍/㎖에서는 32.01%로 확인되었다. 잎 추출물에서는 모든 농도에서 44.15 - 46.46%로 대조군 대비 생존율이 증가하였으며, 꽃 추출물에서는 5 ㎍/㎖에서 59.61%의 높은 생존율과 가지 추출물에서는 농도의존적으로 생존율이 증가하는 경향을 보였다.
UVB에 의해 세포가 자극을 받으면 nitric oxide (NO)의 생산을 유발하고, 생성된 NO로 인하여 세포의 apoptosis가 일어난다. Lee 등 (2001)의 연구에서는 녹차의 주요 성분을 이루고 있는 catechin류 화합물이 세포의 apoptosis에 영향을 주었고 세포자살의 대표적인 특징인 DNA fragmentation이 생성되지 않아 UVB에 대해 보호 효과를 나타낸다고 하였으며, Wu 등 (2006)의 연구에서는 catechin이 UVB로 인해 생성된 H2O2와 JNK 활성화를 억제하여 인간 각질세포의 생존율이 증가하였다고 보고하였다.
Park 등 (2006)의 연구에서 tannic acid는 산화 스트레스를 받은 HaCaT 세포에 대해 세포 보호 효과를 나타내고 UVB에 의해 발생한 p38 MAPK와 ERK 활성화를 모두 억제하여 HaCaT 세포에서 효과적인 항염효과를 보여주었는데, 차나무씨에는 이러한 tannic acid 성분이 다량으로 들어있는 것이 확인되었다 (Noh et al., 2011). 그 외에도 UVB를 처리한 마우스에 차나무 씨 추출물의 경구투여 시 콜라겐 밀도의 회복과 항산화 효소 활성을 나타내고 matrix metalloproteinase-1 (MMP-1), MMP-3, MMP-9의 UVB유도 발현을 감소시켜 UVB 조사에 의한 피부 광노화 및 주름 형성 방지에 효과적이라는 연구 결과가 있다 (Lim et al., 2014). 본 실험을 통하여 차나무 부위별 추출물은 자외선으로부터 세포 보호 효과가 있음을 확인하였다.
차나무는 주로 녹차로 가공하여 음용하며 전 세계적으로 널리 재배되고 있는 품종이다. 차나무 잎으로 만든 녹차는 다양한 생리 활성 성분을 함유하고 있으며 건강 및 미용 목적으로 사용되어 왔다. 그러나 차나무 잎을 제외한 나머지 부위인 꽃, 뿌리, 가지, 씨 등은 대부분이 폐기자원으로 분류되어 버려지고 있다. 본 실험에서는 차나무 부위별 추출물의 생리활성을 확인하여 화장품 원료로써의 활용 가능성을 확인하였다.
차나무의 각 부위인 잎, 꽃, 뿌리, 가지, 씨를 70% 에탄올로 추출하여 tyrosinase 저해 활성, elastase 저해 활성, 여드름 유발균에 대한 항균활성 및 UVB 조사에 따른 세포 생존율을 측정하였다. Tyrosinase 저해 활성은 잎, 꽃, 뿌리에서 높게 나타났고, elastase 저해 활성은 뿌리, 잎, 가지에서 높은 저해율을 보여주었다. P. acnes에 대한 항균 활성은 잎과 뿌리에서 높았고, 그 다음으로 가지, 꽃 순서로 저해 활성을 보여주었으며 씨에서는 항균 활성이 보이지 않았다.
UVB 조사에 따른 세포손상 보호 효과는 HaCaT 세포에서 씨 추출물을 처리한 실험군이 매우 우수한 효능을 나타내었다. Detroit 세포에서는 추출물을 처리한 대부분의 실험군에서 생존율이 향상된 것을 확인할 수 있었으며, 특히 씨와 꽃에서 높은 생존율을 보여주었다. 본 실험의 결과를 통해 차나무의 잎 외의 꽃, 뿌리, 가지, 씨 등의 각종 부위를 화장품 원료로 사용할 수 있을 것으로 생각한다.
References
-
Bom S, Jorge J, Ribeiro HM and Marto J. (2019). A step forward on sustainability in the cosmetics industry: A review. Journal of Cleaner Production. 225:270-290.
[https://doi.org/10.1016/j.jclepro.2019.03.255]

-
Cai L, Qin X, Xu Z, Song Y, Jiang H, Wu Y, Ruan H and Chen J. (2019). Comparison of cytotoxicity evaluation of anticancer drugs between real-time cell analysis and CCK-8 method. ACS Omega. 4:12036-12042.
[https://doi.org/10.1021/acsomega.9b01142]

- Cha WS, Cho MJ, Ding JL and Shin HJ. (2008). Nutritional component analysis of green tea tree's root and seed. Korean Society for Biotechnology and Bioengineering Journal. 23:387-391.
- Chaikul P, Sripisut T, Chanpirom S and Ditthawutthikul N. (2020). Anti-skin aging activities of green tea(Camellia sinensis (L) Kuntze) in B16F10 melanoma cells and human skin fibroblasts.European Journal of Integrative Medicine. 40:101212. https://www.sciencedirect.com/science/article/pii/S1876382020313937, (cited by 2022 April 28).
-
Chen D, Chen G, Sun Y, Zeng X and Ye H. (2020). Physiological genetics, chemical composition, health benefits and toxicology of tea(Camellia sinensis L.) flower: A review. Food Research International. 137:109584. https://www.sciencedirect.com/science/article/pii/S0963996920306098, (cited by 2022 April 28).
[https://doi.org/10.1016/j.foodres.2020.109584]

-
Chen Y, Zhou Y, Zeng L, Dong F, Tu Y and Yang Z. (2018). Occurrence of functional molecules in the flowers of tea (Camellia sinensis) plants: Evidence for a second resource. Molecules. 23:790. https://www.mdpi.com/1420-3049/23/4/790, (cited by 2022 April 28).
[https://doi.org/10.3390/molecules23040790]

- Choi EY, Sohn HY and Lee JT. (2019). The antioxidant and anti-aging effects of treatment with Schisandra chinensis seeds fractions in UVB-irradiated human HaCaT cells. Journal of Life Science. 29:1071-1079.
-
Diffey BL. (2002). Sources and measurement of ultraviolet radiation. Methods. 28:4-13.
[https://doi.org/10.1016/S1046-2023(02)00204-9]

-
Dissanayake CY, Moon HH, Yang KM, Lee YJ and Han CH. (2018). The effects of green tea(Camellia sinensis) flower extract on melanin synthesis in B16-F10 melanoma cells.Korean Journal of Veterinary Research. 58:65-72.
[https://doi.org/10.14405/kjvr.2018.58.2.65]

-
Gan RY, Li HB, Sui ZQ and Corke H. (2018). Absorption, metabolism, anti-cancer effect and molecular targets of epigallocatechin gallate(EGCG): An updated review.Critical Reviews in Food Science and Nutrition.58:924-941.
[https://doi.org/10.1080/10408398.2016.1231168]

-
Hajiaghaalipour F, Kanthimathi MS, Abdulla MA and Sanusi J. (2013). The effect of Camellia sinensis on wound healing potential in an animal model.Evidence-Based Complementary and Alternative Medicine. 2013. https://www.hindawi.com/journals/ecam/2013/386734/, (cited by 2022 April 26).
[https://doi.org/10.1155/2013/386734]

-
Higaki S. (2003). Lipase inhibitors for the treatment of acne. Journal of Molecular Catalysis B: Enzymatic. 22:377-384.
[https://doi.org/10.1016/S1381-1177(03)00053-5]

-
Hodgson JM, Puddey IB, Burke V, Beilin LJ and Jordan N. (1999). Effects on blood pressure of drinking green and black tea. Journal of Hypertension. 17:457-463.
[https://doi.org/10.1097/00004872-199917040-00002]

-
Im SH and Kim JS. (2022). Physicochemical properties of extracts from different parts of Camellia sinensis. Korean Journal of Medicinal Crop Science. 30:195-203.
[https://doi.org/10.7783/KJMCS.2022.30.3.195]

-
Imokawa G and Ishida K. (2015). Biological mechanisms underlying the ultraviolet radiation-induced formation of skin wrinkling and sagging I: Reduced skin elasticity, highly associated with enhanced dermal elastase activity, triggers wrinkling and sagging. International Journal of Molecular Sciences. 16:7753-7775. https://www.mdpi.com/1422-0067/16/4/7753, (cited by April 28).
[https://doi.org/10.3390/ijms16047753]

-
Jiang CB, Chang MJ, Wen CL, Lin YP and Hsu FL. (2006). Natural products of cosmetics analysis of extracts of plants endemic to Taiwan for the presence of tyrosinase-inhibitory, melanin-reducing, and free radical scavenging activities. Journal of Food and Drug Analysis. 14:346-352.
[https://doi.org/10.38212/2224-6614.2451]

-
Ko HM, Eom TK, Kim KC, Yoo JH, Lim JD, Yoo CY and Kim JS. (2018). Biological activity investigation of supercritical fluid extract of fermented mountain ginseng adventitious root. Journal of Advanced Engineering and Technology. 11:115-121.
[https://doi.org/10.35272/jaet.2018.11.2.115]

-
Korkmaz N, Sener SO, Akkaya S, Badem M, Aliyazicioglu R, Abudayyak M, Oztas E and Ozgen U. (2019). Investigation of antioxidant, cytotoxic, tyrosinase inhibitory activities, and phenolic profiles of green, white, and black teas. Turkish Journal of Biochemistry. 44:278-288.
[https://doi.org/10.1515/tjb-2017-0345]

- Kwak YJ, Lee DH, Kim NM and Lee JS. (2005). Screening and extraction condition of anti-skin aging elastase inhibitor from medicinal plants. Korean Journal of Medicinal Crop Science. 13:213-216.
- Lee EH, Lee JK, Hong JT, Jung KM, Kim YK, Lee SH, Chung SY and Lee YW. (2001). Protective effect of green tea extract, catechin on UVB-induced skin damage. Journal of Food Hygiene and Safety. 16:117-124.
-
Lee JH, Shim JS, Chung MS, Lim ST and Kim KH. (2009). In vitro anti-adhesive activity of green tea extract against pathogen adhesion. Phytotherapy Research. 23:460-466.
[https://doi.org/10.1002/ptr.2609]

-
Lee KO, Kim SN and Kim YC. (2014). Anti-wrinkle effects of water extracts of teas in hairless mouse. Toxicology Research. 30:283-289.
[https://doi.org/10.5487/TR.2014.30.4.283]

-
Lee LS, Kim SH, Park JD, Kim YB and Kim YC. (2015). Physicochemical properties and antioxidant activities of loose-leaf green tea commercially available in Korea. Korean Journal of Food Science and Technology. 47:419-424.
[https://doi.org/10.9721/KJFST.2015.47.4.419]

-
Lee YS, Kang YJ and Ryu MJ. (2020). Antibacterial effect and deodorization effect of extracts from different parts of Zingiber officinale. Asian Journal of Beauty and Cosmetology. 18:521-531.
[https://doi.org/10.20402/ajbc.2020.0070]

-
Lim JY, Kim OK, Lee JM, Lee MJ, Kang NG and Hwang JK. (2014). Protective effect of the standardized green tea seed extract on UVB-induced skin photoaging in hairless mice. Nutrition Research and Practice. 8:398-403.
[https://doi.org/10.4162/nrp.2014.8.4.398]

-
Lin YS, Wu SS and Lin JK. (2003). Determination of tea polyphenols and caffeine in tea flowers(Camellia sinensis) and their hydroxyl radical scavenging and nitric oxide suppressing effects. Journal of Agricultural and Food Chemistry. 51:975-980.
[https://doi.org/10.1021/jf020870v]

-
Moore RJ, Jackson KG and Minihane AM. (2009). Green tea (Camellia sinensis) catechins and vascular function. British Journal of Nutrition. 102:1790-1802.
[https://doi.org/10.1017/S0007114509991218]

- Na HW, Lee YR, Park JS, Lee TR and Kim HJ. (2018). Green tea root is a potential natural surfactant and is protective against the detrimental stimulant PM2.5 in human normal epidermal keratinocytes. Journal of the Society of Cosmetic Scientists of Korea. 44:67-72.
-
Nigam PK. (2009). Adverse reactions to cosmetics and methods of testing. Indian Journal of Dermatology, Venereology and Leprology. 75:10-19.
[https://doi.org/10.4103/0378-6323.45214]

-
Noh KH, Jang JH, Min KH, Chinzorig R, Lee MO and Song YS. (2011). Suppressive effect of green tea seed coat ethyl acetate fraction on inflammation and its mechanism in RAW264.7 macrophage cell. Journal of the Korean Society of Food Science and Nutrition.40:625-634.
[https://doi.org/10.3746/jkfn.2011.40.5.625]

-
Paiva L, Lima E, Motta M, Marcone M and Baptista J. (2020). Variability of antioxidant properties, catechins, caffeine, L-theanine and other amino acids in different plant parts of Azorean Camellia sinensis. Current Research in Nutrition and Food Science. 3:227-234.
[https://doi.org/10.1016/j.crfs.2020.07.004]

-
Park HJ, Kim HJ, Kwon HJ, Lee JY, Cho BK, Lee WJ, Yang Y and Cho DH. (2006). UVB-induced interleukin 18 production is downregulated by tannic acids in human HaCaT keratinocytes. Experimental Dermatology. 15:589-595.
[https://doi.org/10.1111/j.1600-0625.2006.00449.x]

-
Prota G. (1980). Recent advances in the chemistry of melanogenesis in mammals.Journal of Investigative Dermatology. 75:122-127.
[https://doi.org/10.1111/1523-1747.ep12521344]

-
Rahardiyan D. (2019). Antibacterial potential of catechin of tea (Camellia sinensis) and its applications. Food Research. 3:1-6.
[https://doi.org/10.26656/fr.2017.3(1).097]

-
Sharma A, Gupta S, Sarethy IP, Dang S and Gabrani R. (2012). Green tea extract: Possible mechanism and antibacterial activity on skin pathogens.Food Research. 135:672-675.
[https://doi.org/10.1016/j.foodchem.2012.04.143]

-
Shin HJ, Jeong HL, Hwang D and Kim DU. (2014). Cudrania tricuspidata root extract as whitening and antiwrinkle cosmetic agent. Korean Journal of Chemical Engineering. 52:701-705.
[https://doi.org/10.9713/kcer.2014.52.6.701]

-
Tu PTB and Tawata S. (2015). Anti-oxidant, anti-aging, and anti-melanogenic properties of the essential oils from two varieties of Alpinia zerumbet. Molecules. 20:16723-16740. https://www.mdpi.com/1420-3049/20/9/16723/htm, (cited by April 28).
[https://doi.org/10.3390/molecules200916723]

- Vishnoi H, Bodla RB, Kant R and Bodla RB. (2018). Green tea(Camellia sinensis) and its antioxidant property: A review. International Journal of Pharmaceutics.9:1723-36.
- Weon JB, Ahn JH and Ma CJ. (2011). Antibacterial activity of some medicinal plants against Propionibacterium acnes. Korean Journal of Pharmacognosy. 42:98-101.
-
Wu WB, Chiang HS, Fang JY, Chen SK, Huang CC and Hung CF. (2006). (+)-Catechin prevents ultraviolet B-induced human keratinocyte death via inhibition of JNK phosphorylation. Life Sciences. 79:801-807.
[https://doi.org/10.1016/j.lfs.2006.02.028]

-
Yang Z, Tu Y, Baldermann S, Dong F, Xu Y and Watanabe N. (2009). Isolation and identification of compounds from the ethanolic extract of flowers of the tea(Camellia sinensis) plant and their contribution to the antioxidant capacity. LWT-Food Science and Technology. 42:1439-1443.
[https://doi.org/10.1016/j.lwt.2009.03.017]

-
Yoshikawa M, Morikawa T, Yamamoto K, Kato Y, Nagatomo A and Matsuda H. (2005). Floratheasaponins A-C, acylated oleanane-type triterpene oligoglycosides with anti-hyperlipidemic activities from flowers of the tea plant(Camellia sinensis). Journal of Natural Products. 68:1360-1365.
[https://doi.org/10.1021/np0580614]

-
You JK, Chung MJ, Kim DJ, Seo DJ, Park JH, Kim TW and Choe M. (2009). Antioxidant and tyrosinase inhibitory effects of Paeonia suffruticosa water extract.Journal of the Korean Society of Food Science and Nutrition. 38:292-296.
[https://doi.org/10.3746/jkfn.2009.38.3.292]

- Zhang L, Li M, Li X, Yan P, Zhang L and Han W. (2021). Summer pruning improves the branch growth and tea quality of tea trees(Camellia sinensis). Acta Physiologiae Plantarum. 43:1-12.
